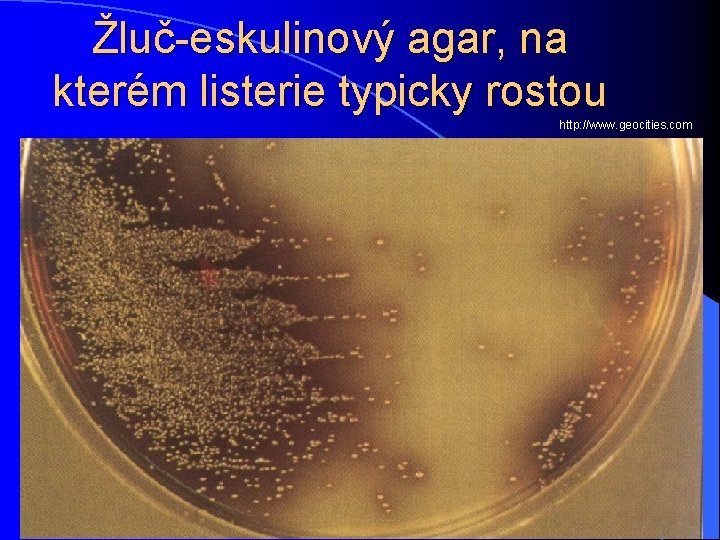
Žluč-eskulinový agar, na kterém listerie typicky rostou http: //www. geocities. com

Perinatln infekce Klinick mikrobiologie BZKM 021 p c

Perinatální infekce Klinická mikrobiologie – BZKM 021 p + c Téma 7 A Ondřej Zahradníček

Pro zopakování: Infekce související s těhotenstvím a porodem Infekce plodu: infekce kongenitální (vrozené, intrauterinní, téma 5 A a 6 A) l Infekce plodu těsně před porodem: prenatální. Plod může být ohrožen i infekcí matky, která na plod přímo nepřestoupila, mění se však fyziologický stav matky l Infekce při porodu: perinatální (téma 7 A) l Infekce po porodu: infekce dítěte (postnatální), infekce matky (puerperální) stále ještě specifické (téma 8 A) l

Porod l fyziologický proces l nicméně výrazná zátěž pro matku i dítě. l v dřívějších dobách docházelo k závažným onemocněním i úmrtí dítěte či i rodičky l mezi příčinami významný podíl infekce Dnes l novorozenecká úmrtnost u nás jedna z nejnižších na světě l dáno mimo jiné dostupností zdravotní péče l porody vedené lékařem nebo možnost přivolání lékařské pomoci

Budoucnost l porodní domy bez účasti lékaře? l pouze pro bezproblémové případy; ale lze všechny komplikace odhadnout předem? l v každém případě velká zodpovědnost porodních asistentek, které vedou porod bez účasti lékaře l musí být schopny rozeznat hrozící nebezpečí l mít vždy v záloze rychlé řešení při komplikaci

Porod doma www. open. ac. uk

Pojmy l Perinatální infekce = získané během porodu l Postnatální infekce = získané později l Někdy "neonatální infekce", protože není jasné, kdy byly získány. Při použití tohoto pojmu platí následující dělení: – časné (zpravidla do 4. dne po porodu) = zpravidla perinatální – pozdní (později) = zpravidla postnatální, ale např. streptokokové a listeriové meningitidy jsou perinatální a příznaky mohou mít později

Charakteristika perinatální infekce l Cesta: – infikovanými porodními cestami – méně často matčinou krví l Nebezpečí hrozí zvláště při předčasném odtoku plodové vody l Na rozdíl od kongenitálních infekcí zde častěji bakterie

Chlamydia trachomatis – serotypy D až K l Jedno z nejčastějších pohlavně přenosných agens ve vyspělých zemích. l U žen často asymptomatická či s minimálními příznaky. l Riziko infekce při porodu je 60 až 70 %. – U 20– 50 % novorozenců konjunktivitida – U 10– 20 % pneumonie l Diagnostika průkazem antigenu nebo nukleové kyseliny l V léčbě makrolidy

/info. fujita-hu. ac. jp www. uni-duesseldorf. de

Chlamydia trachomatis www. medimix. hu onemocnění závisí na serotypu: l Serotypy L 1, L 2, La 2 a L 3 l – vyvolávají tropickou pohlavní nemoc - lymphogranuloma venereum. l Serotypy D až K – způsobují pohlavně přenosná onemocnění ve – – vyspělých zemích často bez příznaků možné záněty různých částí pohlavního ústrojí možná neplodnosti mohou též způsobit záněty spojivky – paratrachom

Chlamydia trachomatis l Serotypy A, B, Ba a C – způsobují trachom – nejčastější příčinu slepoty v rozvojových zemích – postižen téměř každý desátý obyvatel zeměkoule (tj. asi půl miliardy lidí!) – začíná jako zánět spojivek – slepota přichází během 25– 30 let – přenos dotykem a nespecifickými přenašeči (mouchy).

Trachom http: //microbewiki. kenyon. edu/index. php/Image: Trachoma. jpg

Kapavka l poměrně časté onemocnění. l i zde hrozí konjunktivitida, tzv. blenorrhoea neonatorum. l původce však choulostivější, reaguje dobře na tzv. crédeisaci. l crédeisace se provádí u všech dětí, dnes Ophthalmo-Septonexem nebo Ophthalmo. Framykoinem)

http: //www. warwickshire. gov. uk http: //medicine. plosjournals. org Gonokoky http: //www. ratsteachmicro. com www. medmicro. info, foto O. Z.

leukocyt s gonokoky www. medmicro. info

Infekce Streptococcus agalactiae („GBS“) l l l l GBS = SAG (Group B streptococcus = skupina B dle Lancefieldové = Streptococcus agalactiae) U žen bezpříznakový, i když občas i potíže. Časné novorozenecké infekce 2 až 3 na 1000 dětí Méně často jako pozdní novorozenecké infekce. Infekce nejčastěji začíná mezi 20 a 48 hodinami. Děti často předčasně narozené. Infekce dýchacích cest, sepse, hnisavé meningitidy (ty mohou začít i později)

Streptokoky – přehled skupin Příběh Na KA Jméno pachatele 4. 5. viri- dace (alfa) 1. Streptococcus pneumoniae skupina „ústních streptokoků“ Streptococcus pyogenes 3. (beta) Streptococcus agalactiae hemo- lýza* Skupina „non-A-non-B“ streptokoků - žádná 2. Streptokoky bez hemolýzy („gamáči“) *u S. agalactiae jen částečná hemolýza

Seroskupiny dle Lancefieldové l „GBS“ by měl pozitivní aglutinaci s protilátkou proti skupině B (nikoli proti A, jako je na obrázku) http: //www. medicine. uiowa. edu http: //www. pro-lab. com

Screening "SAG" l Provádí se poševní výtěr. Nutno značit, že jde o screening l V laboratoři – normální kultivace na běžné patogeny, plus – speciální selektivně pomnožovací bujón – nebo speciální chromogenní půda – oboje s cílem zvýšit šanci na záchyt streptokoka mezi běžnou vaginální mikroflórou.

Otázky Rektální výtěry? l Kdy provádět screening? l Mikrobiologové doporučují l Někteří porodníci (zvyšuje se záchyt) doporučují co nejpozději (ale hrozí, že při l Gynekologové považují předčasném porodu již za zbytečné (drahé) nestačí být proveden) l V USA vaginorektální výtěr (tampon postupně l Mikrobiologové tvrdí, že zasunut do obou otvorů, v naprosté většině případů z ekonomických důvodů); je zřejmě mikrob přítomen v pochvě již dlouhé týdny sporné, příliš mnoho před porodem a nemá různé kontaminující smysl čekat mikroflóry l

V případě pozitivity screeningu l Těhotná se nepřeléčuje (na rozdíl od případu, kdy se S. agalactiae zachytí před těhotenstvím) l Doporučuje se antibiotická profylaxe při porodu, pokud není veden císařským řezem. Foto O. Z.

Infekce „SAG“ http: //www. meningitis. com. au

Infekce Listeria monocytogenes l Může k infekci dojít jak před porodem, tak i při něm l I zde žena může být zcela bez potíží. l Cca po pěti dnech obraz hnisavé meningitidy, podobný infekci Streptococcus agalactiae l Nebo jiné závažné infekce (záněty plic, meningitidy)
Žluč-eskulinový agar, na kterém listerie typicky rostou http: //www. geocities. com

Screening a léčba listeriózy l Screening se neprovádí l Mikrob se však zachytí při běžném kultivačním vyšetření. l Pro léčbu je doporučena vysoká dávka ampicilinu. l Zcela neúčinné jsou cefalosporiny, stejně jako v případě enterokoků.

Kandidóza l Může rovněž dojít k infekci novorozence, především u nezralých novorozenců l Často se vyskytuje soor (moučnivka) v dutině ústní l Léčba je lokální. http: //www. bmb. leeds. ac. uk/mbiology/ug /ugteach/icu 8/std/candidgram. html

Hepatitidy l V průběhu porodu může dojít k přenosu hepatitid, zejména B a C. l U hepatitidy B má novorozenec infikovaný při porodu 80% riziko chronického nosičství l U hepatitidy C chronicita také častá. l Přitom při porodu matky s virémií je 7% riziko přenosu na dítě.

Genitální herpes (opar) l l l Infekce perinatální častější než kongenitální K příznakům může patřit kromě postižení kůže i postižení jater a CNS. Screening není nutný, neboť příznaky infekce jsou klinicky patrné Pokud patrné nejsou, je riziko přenosu minimální Základem úspěchu pečlivé předporodní vyšetření V případě aktivního oparu v porodních cestách je indikován císařský řez. Papilomavirové infekce: vzácně vyvolat tvorba papilomů v hrtanu novorozence

Herpes http: //health. nytimes. com

Kongenitální herpes http: //farm 4. static. flickr. com

Perinatální varicela www. aap. org/pressroom/aappr-photos. htm

Laboratorní průkaz novorozeneckých infekcí Odběr odpovídá klinickým příznakům a situaci. l Před porodem l – poševní výtěr – odtékající plodová voda l Po porodu – hemokultivace (do speciálních pediatrických lahviček) – další vzorky (z dýchacích cest, mozkomíšní mok. . . ) Zvláštní způsob odběru nutný u některých patogenů (Chlamydia trachomatis na suchém tamponu) l Uvést na průvodku, o jaké vyšetření jde l

Obecné poznámky k léčbě perinatálních infekcí l V empirické léčbě perinatálních infekcí (tedy než se najde původce) se často používá ampicilin l Postihuje nejčastější původce (zejména streptokoky a listerie). l Je ovšem vždy třeba modifikovat léčbu podle mikrobiologického nálezu.

Děkuji za pozornost
- Slides: 34